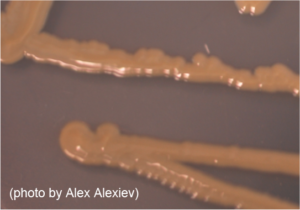

While the San Francisco 49ers and the New England Patriots may not be playing in the Super Bowl this Sunday at the Meadowlands, they will be participating in a Super Bowl onboard the International Space Station in March! That’s right, a Microbial Super Bowl.
Science Cheerleader Talmesha Richards explains the connection in the following post, originally posted on Teach For America’s Pass the Chalk Blog. It’s reposted here with permission.
By Talmesha Richard, PhD
Picture it.
It’s the NFC Championship game and with only minutes left the game is tied between the Seattle Seahawks and the San Francisco 49ers. Seattle Seahawks’ Richard Sherman tips the ball out of the hands of the San Francisco 49ers’ Michael Crabtree. Sherman’s teammate, Malcolm Smith, catches the ball in the end-zone and ends the game.
That one moment was the difference between the 49ers heading to the Super Bowl or heading home.
While the San Francisco 49ers and, as it turns out, the New England Patriots may not be playing in the Super Bowl this Sunday at the Meadowlands, they will be participating in a Super Bowl onboard the International Space Station! That’s right, a Microbial Super Bowl. “What is that?” you ask? Read on and you’ll see exactly what I mean.
Every person I’ve met in Science, Technology, Engineering and Mathematics (STEM) has had that one moment that piqued their interest in STEM. It could have been a trip to the Smithsonian Air and Space Museum or maybe an indescribable intuitive reaction to take your computer apart to see how it works.
For me, that one moment was when my third grade teacher, Mrs.Brown, saw me trying to complete my multiplication quiz using my fingers. She talked to me after class and explained that there were different tricks to solving multiplication problems. Mrs. Brown opened my eyes to a whole new world and she taught me that math could be fun and so powerful. I was hooked and my love for science quickly followed.
I grew up in what some may call Baltimore’s “inner city.” My parents, who always stressed the importance of a good education, recognized my interest in STEM and nurtured it through various programs throughout my elementary and secondary education. I became a Meyerhoff Scholar at the University of Maryland Baltimore County and graduated with a B.S. in Chemical Engineering and a B.S. in Mathematics. For graduate school, I attended the Johns Hopkins School of Medicine and graduated with a Ph.D. in Cellular and Molecular Medicine.
Not only did I love mathematics and science, I also loved the arts from painting to dancing. I am a firm believer in nurturing my academic and artistic sides. This passion led me to cheering three years with the Baltimore Ravens Cheerleaders and five years with the Washington Redskins Cheerleaders. This makes me a Science Cheerleader.

Science Cheerleaders and Pop Warner cheerleaders set Guinness World Record for Largest Cheerleading Cheer (cheered for Science, of course!)
Science Cheerleader is an organization consisting of more than 250 current and former professional cheerleaders from the NFL, NBA, and other pro sports leagues, who are pursuing STEM careers. The mission of the Science Cheerleader is to playfully challenge stereotypes and inspire young women to consider STEM careers. Thousands of college, high school and middle school cheerleaders with interests in STEM are poised to join our mission. We hope, through our partnership with Pop Warner Little Scholars, for example, we’ll spark interest in science among their 100,000 young cheerleaders each year!
Another goal of Science Cheerleader is to increase public understanding of, and engagement in, STEM. While many people may never pursue a STEM career we strive to connect people to the thousands of opportunities out there for them to get involved in formal and informal research projects (more commonly known as “citizen science”) through our sister-site, SciStarter.
One such research project is Project MERCCURI: Microbial Ecology Research Combining Citizen and University Researchers on International Space Station. Science Cheerleaders have partnered with UC Davis to engage thousands of people from all walks of life to help collect microbes from public events, landmarks and stadiums across the country as well as from shoes and cellphones. We want to learn how microbes from different places on Earth compare to each other and to those found on the International Space Station.

Project MERCCURI Mission Patch
In addition to the thousands of samples being sequenced at Argonne National Lab, 48 microbial samples have been cultured and selected by UC Davis and approved by NASA to fly on the International Space Station in March where they will be studied for their growth rates and other behaviors in a near-zero gravity environment. Astronauts will swab the inside of the ISS as part of this research to compare microbes of the built environement. All the findings will be open to the public. Follow along at SpaceMicrobes.org!
Two of the 48 samples being sent into space via the Space X rocket are from the stadiums of the NFL New England Patriots and the San Francisco 49ers. (Other participating NFL teams include the TN Titans, Oakland Raiders, Washington Redskins, Miami Dolphins, and AZ Cardinals.)
Even though these two teams will not be in the Super Bowl this Sunday, they will duke it out in the Microbial Super Bowl, seeing who’s the “best sprinter” and “best huddler.” The best sprinter is the microbial competitor that can grow the fastest in a near zero-g environment, during the sprinting portion of growth also known as the exponential growth phase. The best huddler is the microbial competitor who can grow to the highest density.
Cheers to the Microbial Super Bowl! Who will you be cheering for? As for me and all the Science Cheerleaders, we’ll be rooting for all the Project MERCCURI citizen scientists, including all those youth Pop Warner cheerleaders!
It is quite possible that through Project MERCCURI, there’s a kid who had her one moment, realizing that she CAN be a scientist. We may never know, but it’s so rewarding be part of an organization that presents inspiring and empowering opportunities for kids and adults to see themselves in a different light.
Oh, and just wait until you see what we’ve got going on with the NBA!
Editor’s note:
Let’s take a look at Patriots and 49ers’ microbial stats, courtesy of trading cards created by UC Davis:
The New England Patriots Cheerleaders swabbed their field.

Here’s what the researchers at UC Davis found:

Bacillus amyloliquefaciens
Why it’s awesome: This is an important industrial organism, used for the production of enzymes that degrade protein, such as those used in contact lens cleaner
Fun fact: A strain of this bacteria found on plants has been shown to produce a variety of potential “biocontrol” agents that might be used to battle plant pathogens
The San Francisco 49ers swabbed their field.

49ers Gold Rush cheerleader Kayla swabbing the field
Exiguobacterium acetylicum
Why it’s awesome: This soil microbe helps plants to grow by inhibiting the spread of pathogenic fungi
Fun fact: A cold-tolerant strain of this microbe from the Himalayas was found to help wheat seeds germinate at very low soil temperatures
Other NFL teams participating in Project MERCCURI include the TN Titans, Oakland Raiders, Miami Dolphins, and Washington Redskins.
Speaking of the NFL, here’s a link to a video series we worked on with the NFL, NBC and the National Science Foundation, “The Science of NFL Football.”